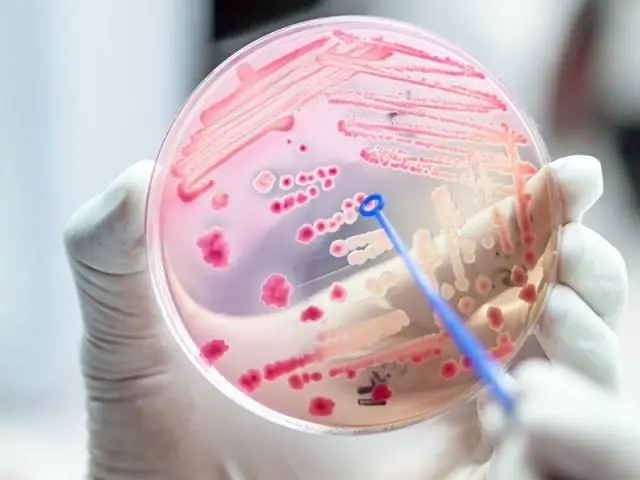
Развитые в лаборатории бактерии переходят на потребление углекислого газа для роста

В течение нескольких месяцев исследователи в Израиле создали штаммы кишечной палочки, которые потребляют CO2 для получения энергии вместо органических соединений. Это достижение синтетической биологии подчеркивает невероятную пластичность бактериального метаболизма и может стать основой для будущего углеродно-нейтрального биопродукции. Работа появится 27 ноября в журнале Cell.
Наша главная цель состояла в том, чтобы создать удобную научную платформу, которая могла бы улучшить фиксацию CO2, что может помочь решить проблемы, связанные с устойчивым производством продуктов питания и топлива и вызванным глобальным потеплением. выбросами CO2», - говорит старший автор Рон Майло, системный биолог в Институте науки Вейцмана.«Преобразование источника углерода E. coli, рабочей лошадки биотехнологии, из органического углерода в CO2 является важным шагом на пути к созданию такой платформы».
Живой мир делится на автотрофов, преобразующих неорганический CO2 в биомассу, и гетеротрофов, потребляющих органические соединения. Автотрофные организмы преобладают в биомассе на Земле и обеспечивают большую часть нашей пищи и топлива. Лучшее понимание принципов автотрофного роста и методов его повышения имеет решающее значение на пути к устойчивости.
Серьезной задачей синтетической биологии было создание синтетической автотрофии в модельном гетеротрофном организме. Несмотря на широкий интерес к хранению возобновляемой энергии и более устойчивому производству продуктов питания, прошлые попытки разработать промышленно значимые гетеротрофные модельные организмы для использования CO2 в качестве единственного источника углерода не увенчались успехом. Предыдущие попытки установить автокаталитические циклы фиксации CO2 у модельных гетеротрофов всегда требовали добавления многоуглеродных органических соединений для достижения стабильного роста.
С фундаментальной научной точки зрения, мы хотели увидеть, произойдет ли такое серьезное преобразование в питании бактерий - от зависимости от сахара до синтеза всей их биомассы из CO2- возможно», - говорит первый автор Шмуэль Глейзер (@GleizerShmuel), научный сотрудник Института Вейцмана. «Помимо проверки осуществимости такой трансформации в лаборатории, мы хотели знать, насколько необходима экстремальная адаптация с точки зрения изменений в схеме бактериальной ДНК».
В исследовании Cell ученые использовали перестройку метаболизма и лабораторную эволюцию, чтобы превратить E. coli в автотрофов. Сконструированный штамм собирает энергию из формиата, который может быть получен электрохимическим путем из возобновляемых источников. Поскольку формиат представляет собой органическое одноуглеродное соединение, которое не служит источником углерода для роста E. coli, он не поддерживает гетеротрофные пути. Исследователи также разработали штамм для производства неродных ферментов для фиксации и восстановления углерода, а также для сбора энергии из формиата. Но одних этих изменений было недостаточно для поддержания автотрофии, потому что метаболизм E. coli приспособлен к гетеротрофному росту.
Чтобы решить эту проблему, исследователи обратились к адаптивной лабораторной эволюции как к инструменту оптимизации метаболизма. Они инактивировали центральные ферменты, участвующие в гетеротрофном росте, делая бактерии более зависимыми от автотрофных путей роста. Они также выращивали клетки в хемостатах с ограниченным запасом сахарной ксилозы - источника органического углерода - для подавления гетеротрофных путей. Первоначальный запас ксилозы примерно на 300 дней был необходим для поддержания достаточной пролиферации клеток, чтобы дать толчок эволюции. Хемостат также содержал большое количество формиата и 10% CO2 атмосферу.
В этой среде автотрофы, производящие биомассу из CO2 в качестве единственного источника углерода, имеют большое избирательное преимущество по сравнению с гетеротрофами, которые зависят от ксилозы в качестве источника углерода для рост. Используя изотопную маркировку, исследователи подтвердили, что эволюционировавшие изолированные бактерии были действительно автотрофными, то есть CO2, а не ксилоза или какое-либо другое органическое соединение, поддерживающее рост клеток..
«Чтобы общий подход лабораторной эволюции увенчался успехом, нам нужно было найти способ совместить желаемое изменение в поведении клеток с преимуществом в фитнесе», - говорит Майло. «Это было сложно и требовало много размышлений и продуманного дизайна».
Секвенировав геном и плазмиды эволюционировавших автотрофных клеток, исследователи обнаружили, что всего 11 мутаций были приобретены в ходе эволюционного процесса в хемостате. Один набор мутаций затронул гены, кодирующие ферменты, связанные с циклом фиксации углерода. Вторая категория состояла из мутаций, обнаруженных в генах, которые обычно мутировали в предыдущих экспериментах по адаптивной лабораторной эволюции, предполагая, что они не обязательно специфичны для автотрофных путей. Третья категория состояла из мутаций в генах с неизвестной ролью.
«Исследование впервые описывает успешную трансформацию способа роста бактерий. Научить кишечную бактерию делать трюки, которыми славятся растения, было очень непросто», - говорит Глейзер. «Когда мы начали направленный эволюционный процесс, у нас не было ни малейшего представления о наших шансах на успех, и в литературе не было прецедентов, которые бы руководили или предполагали осуществимость такой экстремальной трансформации. Кроме того, видя в конце относительно небольшой количество генетических изменений, необходимых для осуществления этого перехода, было удивительным».
Авторы говорят, что одним из основных ограничений исследования является то, что потребление формиата бактериями высвобождает больше CO2, чем потребляется при фиксации углерода. Кроме того, необходимы дополнительные исследования, прежде чем можно будет обсудить масштабируемость подхода для промышленного использования.
В будущей работе исследователи будут стремиться поставлять энергию за счет возобновляемой электроэнергии, чтобы решить проблему выброса CO2, определить, могут ли окружающие атмосферные условия поддерживать автотрофию, и попытаться сузить наиболее релевантные мутации для автотрофного роста.
«Этот подвиг является мощным доказательством концепции, которая открывает новую захватывающую перспективу использования сконструированных бактерий для преобразования продуктов, которые мы считаем отходами, в топливо, пищу или другие представляющие интерес соединения», - говорит Майло. «Он также может служить платформой для лучшего понимания и улучшения молекулярных машин, которые являются основой производства продуктов питания для человечества и, таким образом, помогут в будущем увеличить урожайность в сельском хозяйстве».